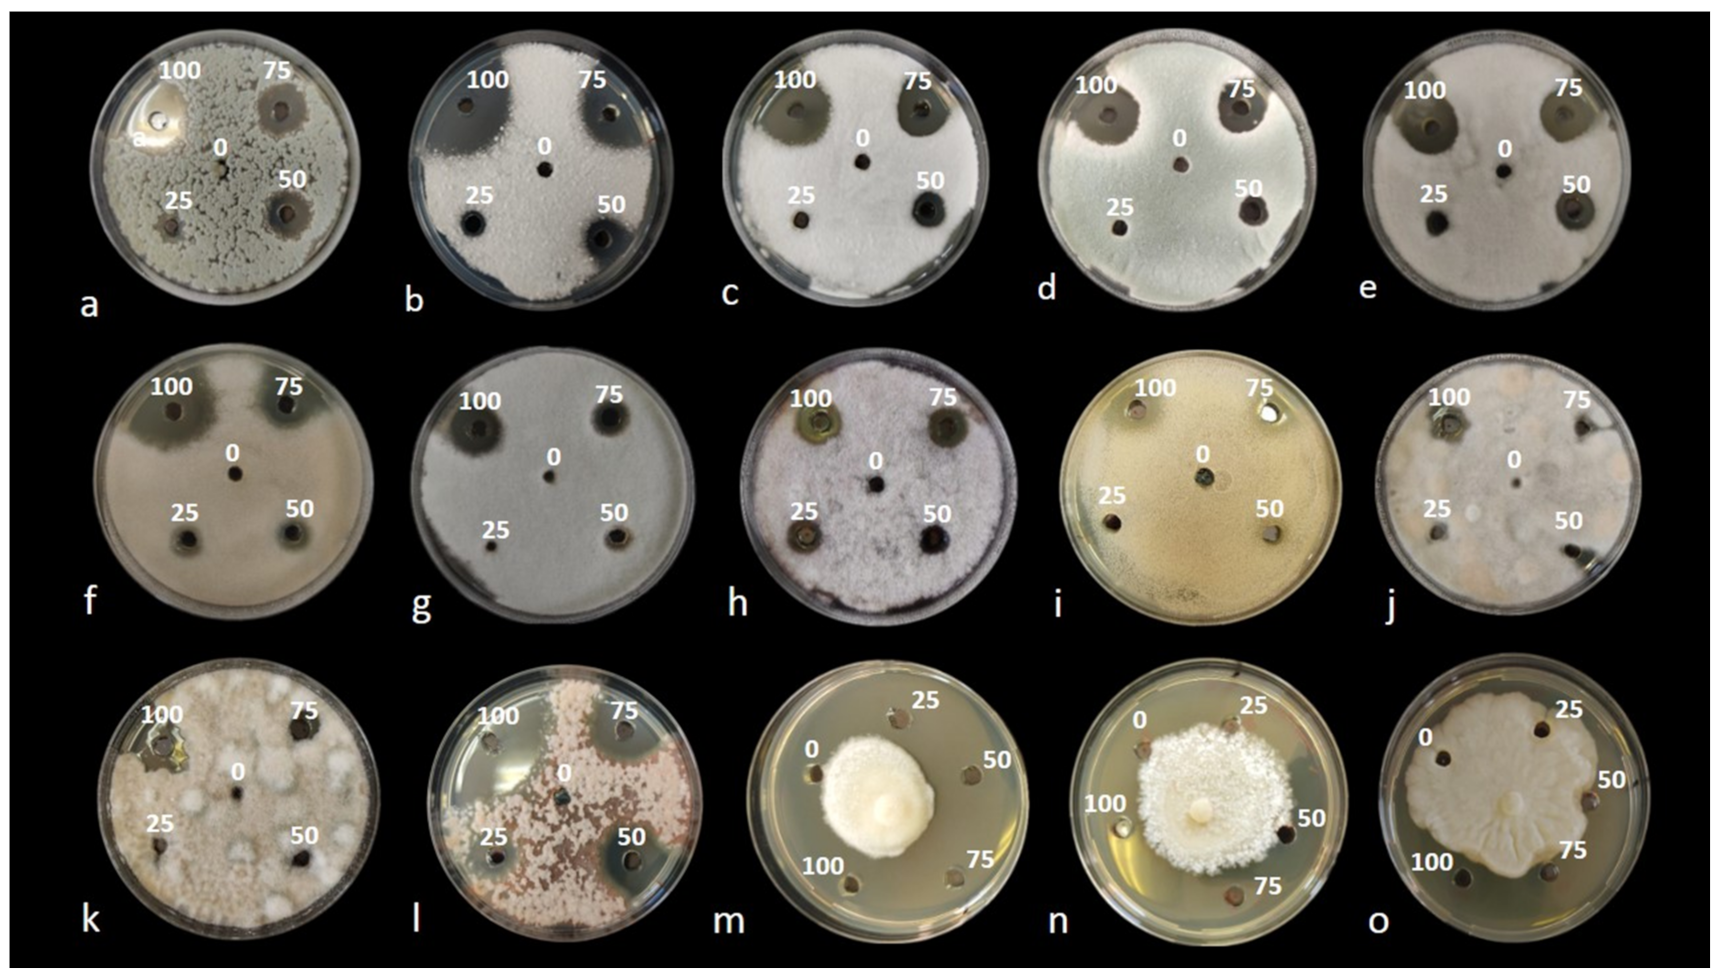

Inhibitory Activity of Shrimp Waste Extracts on Fungal and Oomycete Plant Pathogens
Abstract
:1. Introduction
2. Results
2.1. Metabolites and Phenolic Compounds Detected in Test Substances by HPLC-ESI-MS/TOF
2.2. In Vitro Preliminary Tests
2.3. Determination of MIC and MFC
2.4. In Vivo Antifungal Activity
2.4.1. Antifungal Activity on Oranges
2.4.2. Antifungal Activity on Lemons
2.4.3. Antifungal Activity on Apples
3. Discussion
4. Materials and Methods
4.1. Preparation of Shrimp Waste Substances
4.2. Analysis of Metabolites Present in Shrimp Waste Samples by HPLC-ESI-MS/TOF
4.3. Fungal and Oomycete Strains, Culture Conditions and Propagules Production
4.4. In Vitro Preliminary Screening for Selecting the Most Effective Extract
4.5. Minimum Inhibitory Concentration (MIC) and Minimum Fungicidal Concentration (MFC) of Nitric-Extract
4.6. Evaluating the In Vivo Antifungal Activity of Nitric-Extract in Preventing Fruit Rots
4.6.1. Nitric-Extract Dilutions
4.6.2. Fruits
4.6.3. Fungal Pathogens and Inoculum Preparation
4.6.4. Inoculation
4.6.5. Evaluation of the Efficacy of the Nitric-Extract in Preventing Fruit Rot
Author Contributions
Funding
Institutional Review Board Statement
Informed Consent Statement
Data Availability Statement
Acknowledgments
Conflicts of Interest
References
- Korukluoglu, M.; Sahan, Y.; Yigit, A. Antifungal Properties of Olive Leaf Extracts and Their Phenolic Compounds. J. Food Saf. 2008, 28, 76–87. [Google Scholar] [CrossRef]
- Hernández, A.; Ruiz-Moyano, S.; Galván, A.I.; Merchán, A.V.; Pérez Nevado, F.; Aranda, E.; Serradilla, M.J.; de Guía Córdoba, M.; Martín, A. Anti-fungal activity of phenolic sweet orange peel extract for controlling fungi responsible for post-harvest fruit decay. Fungal Biol. 2021, 125, 143–152. [Google Scholar] [CrossRef] [PubMed]
- Wei, L.; Zhang, J.; Tan, W.; Wang, G.; Li, Q.; Dong, F.; Guo, Z. Antifungal activity of double Schiff bases of chitosan derivatives bearing active halogeno-benzenes. Int. J. Biol. Macromol. 2021, 179, 292–298. [Google Scholar] [CrossRef]
- Meng, D.; Garba, B.; Ren, Y.; Yao, M.; Xia, X.; Li, M.; Wang, Y. Antifungal activity of chitosan against Aspergillus ochraceus and its possible mechanisms of action. Int. J. Biol. Macromol. 2020, 158, 1063–1070. [Google Scholar] [CrossRef] [PubMed]
- Abade, A.; Ferreira, P.A.; de Barros Vidal, F. Plant Diseases recognition on images using Convolutional Neural Networks: A Systematic Review. Comput. Electron. Agric. 2021, 185, 106125. [Google Scholar] [CrossRef]
- Huang, F.-C.; Molnár, P.; Schwab, W. Cloning and functional characterization of carotenoid cleavage dioxygenase 4 genes. J. Exp. Bot. 2009, 60, 3011–3022. [Google Scholar] [CrossRef] [PubMed] [Green Version]
- La Spada, F.; Aloi, F.; Coniglione, M.; Pane, A.; Cacciola, S.O. Natural Biostimulants Elicit Plant Immune System in an Integrated Management Strategy of the Postharvest Green Mold of Orange Fruits Incited by Penicillium digitatum. Front. Plant Sci. 2021, 12, 684722. [Google Scholar] [CrossRef]
- La Spada, F.; Stracquadanio, C.; Riolo, M.; Pane, A.; Cacciola, S.O. Trichoderma Counteracts the Challenge of Phytophthora nicotianae Infections on Tomato by Modulating Plant Defense Mechanisms and the Expression of Crinkler, Necrosis-Inducing Phytophthora Protein 1, and Cellulose-Binding Elicitor Lectin Pathogenic Effectors. Front. Plant Sci. 2020, 11, 583539. [Google Scholar] [CrossRef]
- Stracquadanio, C.; Quiles, J.M.; Meca, G.; Cacciola, S.O. Antifungal Activity of Bioactive Metabolites Produced by Trichoderma asperellum and Trichoderma atroviride in Liquid Medium. JoF 2020, 6, 263. [Google Scholar] [CrossRef]
- du Jardin, P. Plant biostimulants: Definition, concept, main categories and regulation. Sci. Hortic. 2015, 196, 3–14. [Google Scholar] [CrossRef] [Green Version]
- Wang, L.; Wu, H.; Qin, G.; Meng, X. Chitosan disrupts Penicillium expansum and controls postharvest blue mold of jujube fruit. Food Control 2014, 41, 56–62. [Google Scholar] [CrossRef]
- Yang, R.; Miao, J.; Shen, Y.; Cai, N.; Wan, C.; Zou, L.; Chen, C.; Chen, J. Antifungal effect of cinnamaldehyde, eugenol and carvacrol nanoemulsion against Penicillium digitatum and application in postharvest preservation of citrus Fruit. LWT 2021, 141, 110924. [Google Scholar] [CrossRef]
- Girotto, F.; Alibardi, L.; Cossu, R. Food waste generation and industrial uses: A review. Waste Manag. 2015, 45, 32–41. [Google Scholar] [CrossRef]
- Prameela, K.; Venkatesh, K.; Immandi, S.B.; Kasturi, A.P.K.; Rama Krishna, C.; Murali Mohan, C. Next generation nutraceutical from shrimp waste: The convergence of applications with extraction methods. Food Chem. 2017, 237, 121–132. [Google Scholar] [CrossRef]
- Nirmal, N.P.; Santivarangkna, C.; Rajput, M.S.; Benjakul, S. Trends in shrimp processing waste utilization: An industrial prospective. Trends Food Sci. Technol. 2020, 103, 20–35. [Google Scholar] [CrossRef]
- Taser, B.; Ozkan, H.; Adiguzel, A.; Orak, T.; Baltaci, M.O.; Taskin, M. Preparation of chitosan from waste shrimp shells fermented with Paenibacillus Jamilae BAT1. Int. J. Biol. Macromol. 2021, 183, 1191–1199. [Google Scholar] [CrossRef] [PubMed]
- Kandra, P.; Challa, M.M.; Kalangi Padma Jyothi, H. Efficient use of shrimp waste: Present and future trends. Appl. Microbiol. Biotechnol. 2012, 93, 17–29. [Google Scholar] [CrossRef] [PubMed]
- Zhou, Y.; Guo, N.; Wang, Z.; Zhao, T.; Sun, J.; Mao, X. Evaluation of a clean fermentation-organic acid method for processing Sshrimp waste from six major cultivated shrimp Sspecies in China. J. Clean. Prod. 2021, 294, 126135. [Google Scholar] [CrossRef]
- Kumar, A.; Kumar, D.; George, N.; Sharma, P.; Gupta, N. A process for complete biodegradation of shrimp waste by a novel marine isolate Paenibacillus sp. AD with simultaneous production of chitinase and chitin oligosaccharides. Int. J. Biol. Macromol. 2018, 109, 263–272. [Google Scholar] [CrossRef]
- Goossens, Y.; Schmidt, T.G.; Kuntscher, M. Evaluation of Food Waste Prevention Measures—The Use of Fish Products in the Food Service Sector. Sustainability 2020, 12, 6613. [Google Scholar] [CrossRef]
- Cheong, J.Y.; Muskhazli, M.; Nor Azwady, A.A.; Ahmad, S.A.; Adli, A.A. Three dimensional optimisation for the enhancement of astaxanthin recovery from shrimp shell wastes by Aeromonas hydrophila. Biocatal. Agric. Biotechnol. 2020, 27, 101649. [Google Scholar] [CrossRef]
- Roy, V.C.; Getachew, A.T.; Cho, Y.-J.; Park, J.-S.; Chun, B.-S. Recovery and bio-potentialities of astaxanthin-rich oil from shrimp (Peneanus monodon) waste and mackerel (Scomberomous niphonius) skin using concurrent supercritical CO2 extraction. J. Supercrit. Fluids 2020, 159, 104773. [Google Scholar] [CrossRef]
- Shen, Q.; Song, G.; Wang, H.; Zhang, Y.; Cui, Y.; Xie, H.; Xue, J.; Wang, H. Isolation and lipidomics characterization of fatty acids and phospholipids in shrimp waste through GC/FID and HILIC-QTrap/MS. J. Food Compos. Anal. 2021, 95, 103668. [Google Scholar] [CrossRef]
- Pattanaik, S.S.; Sawant, P.B.; Xavier, K.A.M.; Dube, K.; Srivastava, P.P.; Dhanabalan, V.; Chadha, N.K. Characterization of carotenoprotein from different shrimp shell waste for possible use as supplementary nutritive feed ingredient in animal diets. Aquaculture 2020, 515, 734594. [Google Scholar] [CrossRef]
- Santos, V.P.; Marques, N.S.S.; Maia, P.C.S.V.; Lima, M.A.B.d.; Franco, L.d.O.; Campos-Takaki, G.M.d. Seafood Waste as Attractive Source of Chitin and Chitosan Production and Their Applications. Int. J. Mol. Sci. 2020, 21, 4290. [Google Scholar] [CrossRef]
- Eddya, M.; Tbib, B.; EL-Hami, K. A comparison of chitosan properties after extraction from shrimp shells by diluted and concentrated acids. Heliyon 2020, 6, e03486. [Google Scholar] [CrossRef] [PubMed] [Green Version]
- Zhang, Y.; Wang, Y.; Zhang, Z.; Cui, W.; Zhang, X.; Wang, S. Removing copper and cadmium from water and sediment by magnetic microspheres—MnFe2O4/chitosan prepared by waste shrimp shells. J. Environ. Chem. Eng. 2021, 9, 104647. [Google Scholar] [CrossRef]
- Zhang, Z.; Li, C.; Wang, Q.; Zhao, Z.K. Efficient hydrolysis of chitosan in ionic liquids. Carbohydr. Polym. 2009, 78, 685–689. [Google Scholar] [CrossRef]
- Sakko, M.; Moore, C.; Novak-Frazer, L.; Rautemaa, V.; Sorsa, T.; Hietala, P.; Järvinen, A.; Bowyer, P.; Tjäderhane, L.; Rautemaa, R. 2-hydroxyisocaproic acid is fungicidal for Candida and Aspergillus species. Mycoses 2014, 57, 214–221. [Google Scholar] [CrossRef]
- Honoré, A.H.; Aunsbjerg, S.D.; Ebrahimi, P.; Thorsen, M.; Benfeldt, C.; Knøchel, S.; Skov, T. Metabolic footprinting for investigation of antifungal properties of Lactobacillus paracasei. Anal. Bioanal. Chem. 2016, 408, 83–96. [Google Scholar] [CrossRef]
- Krátký, M.; Konečná, K.; Janoušek, J.; Brablíková, M.; Janďourek, O.; Trejtnar, F.; Stolaříková, J.; Vinšová, J. 4-Aminobenzoic Acid Derivatives: Converting Folate Precursor to Antimicrobial and Cytotoxic Agents. Biomolecules 2019, 10, 9. [Google Scholar] [CrossRef] [Green Version]
- Bajpai, V.K.; Kim, H.R.; Hou, C.T.; Kang, S.C. Microbial conversion and in vitro and in vivo antifungal assessment of bioconverted docosahexaenoic acid (bDHA) used against agricultural plant pathogenic fungi. J. Ind. Microbiol. Biotechnol. 2009, 36, 695–704. [Google Scholar] [CrossRef]
- Kumar Patel, M.; Maurer, D.; Feygenberg, O.; Ovadia, A.; Elad, Y.; Oren-Shamir, M.; Alkan, N. Phenylalanine: A Promising Inducer of Fruit Resistance to Postharvest Pathogens. Foods 2020, 9, 646. [Google Scholar] [CrossRef]
- Belgacem, I.; Pangallo, S.; Abdelfattah, A.; Romeo, F.V.; Cacciola, S.O.; Li Destri Nicosia, M.G.; Ballistreri, G.; Schena, L. Transcriptomic Analysis of Orange Fruit Treated with Pomegranate Peel Extract (PGE). Plants 2019, 8, 101. [Google Scholar] [CrossRef] [PubMed] [Green Version]
- Romanazzi, G.; Feliziani, E.; Sivakumar, D. Chitosan, a Biopolymer with Triple Action on Postharvest Decay of Fruit and Vegetables: Eliciting, Antimicrobial and Film-Forming Properties. Front. Microbiol. 2018, 9, 2745. [Google Scholar] [CrossRef] [PubMed]
- Fitzgerald, D.J.; Stratford, M.; Gasson, M.J.; Narbad, A. Structure−Function Analysis of the Vanillin Molecule and Its Antifungal Properties. J. Agric. Food Chem. 2005, 53, 1769–1775. [Google Scholar] [CrossRef] [PubMed]
- Lu, H.-F.; Tsou, M.-F.; Lin, J.-G.; Ho, C.-C.; Liu, J.-Y.; Chuang, J.-Y.; Chung, J.-G. Ellagic Acid Inhibits Growth and Arylamine N-Acetyltransferase Activity and Gene Expression in Staphylococcus Aureus. In Vivo 2005, 19, 195–199. [Google Scholar]
- Kocaçalışkan, I.; Talan, I.; Terzi, I. Antimicrobial Activity of Catechol and Pyrogallol as Allelochemicals. Zeitschrift für Naturforschung C 2006, 61, 639–642. [Google Scholar] [CrossRef]
- Beck, J.J.; Kim, J.H.; Campbell, B.C.; Chou, S.-C. Fungicidal Activities of Dihydroferulic Acid Alkyl Ester Analogues. J. Nat. Prod. 2007, 70, 779–782. [Google Scholar] [CrossRef]
- Ngarmsak, M. Antifungal Activity of Vanillin on Fresh-Cut Tropical Fruits. Acta Hortic. 2007, 409–416. [Google Scholar] [CrossRef]
- Tao, S.; Zhang, S.; Tsao, R.; Charles, M.T.; Yang, R.; Khanizadeh, S. In vitro antifungal activity and mode of action of selected polyphenolic antioxidants on Botrytis Cinerea. Arch. Phytopathol. Plant Prot. 2010, 43, 1564–1578. [Google Scholar] [CrossRef]
- Li, B.; Lai, T.; Qin, G.; Tian, S. Ambient pH Stress Inhibits Spore Germination of Penicillium expansum by Impairing Protein Synthesis and Folding: A Proteomic-Based Study. J. Proteome Res. 2010, 9, 298–307. [Google Scholar] [CrossRef] [PubMed]
- Jeong, M.-H.; Lee, Y.-S.; Cho, J.-Y.; Ahn, Y.-S.; Moon, J.-H.; Hyun, H.-N.; Cha, G.-S.; Kim, K.-Y. Isolation and characterization of metabolites from Bacillus Licheniformis MH48 with antifungal activity against plant pathogens. Microb. Pathog. 2017, 110, 645–653. [Google Scholar] [CrossRef] [PubMed]
- Liu, X.; Ji, D.; Cui, X.; Zhang, Z.; Li, B.; Xu, Y.; Chen, T.; Tian, S. p-Coumaric acid induces antioxidant capacity and defense responses of sweet cherry fruit to fungal pathogens. Postharvest Biol. Technol. 2020, 169, 111297. [Google Scholar] [CrossRef]
- Zamuz, S.; Munekata, P.E.S.; Dzuvor, C.K.O.; Zhang, W.; Sant’Ana, A.S.; Lorenzo, J.M. The role of phenolic compounds against Listeria monocytogenes in food. A review. Trends Food Sci. Technol. 2021, 110, 385–392. [Google Scholar] [CrossRef]
- Khan, F.; Bamunuarachchi, N.I.; Tabassum, N.; Kim, Y.-M. Caffeic Acid and Its Derivatives: Antimicrobial Drugs toward Microbial Pathogens. J. Agric. Food Chem. 2021, 69, 2979–3004. [Google Scholar] [CrossRef]
- Seeram, N.; Adams, L.; Henning, S.; Niu, Y.; Zhang, Y.; Nair, M.; Heber, D. In vitro antiproliferative, apoptotic and antioxidant activities of punicalagin, ellagic acid and a total pomegranate tannin extract are enhanced in combination with other polyphenols as found in pomegranate juice. J. Nutr. Biochem. 2005, 16, 360–367. [Google Scholar] [CrossRef] [PubMed] [Green Version]
- Singh, R.P.; Chidambara Murthy, K.N.; Jayaprakasha, G.K. Studies on the Antioxidant Activity of Pomegranate (Punica granatum) Peel and Seed Extracts Using in Vitro Models. J. Agric. Food Chem. 2002, 50, 81–86. [Google Scholar] [CrossRef]
- Vora, A.; Londhe, V.; Pandita, N. Herbosomes enhance the in vivo antioxidant activity and bioavailability of punicalagins from standardized pomegranate extract. J. Funct. Foods 2015, 12, 540–548. [Google Scholar] [CrossRef]
- Al-Zoreky, N.S. Antimicrobial activity of pomegranate (Punica granatum L.) fruit peels. Int. J. Food Microbiol. 2009, 134, 244–248. [Google Scholar] [CrossRef]
- Tayel, A.A.; El-Baz, A.F.; Salem, M.F.; El-Hadary, M.H. Potential applications of pomegranate peel extract for the control of citrus green mould. J. Plant Dis. Prot. 2009, 116, 252–256. [Google Scholar] [CrossRef]
- Barash, I.; Pupkin, G.; Koren, L.; Ben-Hayyim, G.; Strobel, G.A. A low molecular weight phytotoxin produced by Phoma tracheiphila, the cause of mal secco disease in citrus. Physiol. Plant Pathol. 1981, 19, 17–29. [Google Scholar] [CrossRef]
- Migheli, Q.; Cacciola, S.O.; Balmas, V.; Pane, A.; Ezra, D.; di San Lio, G.M. Mal Secco Disease Caused by Phoma tracheiphila: A Potential Threat to Lemon Production Worldwide. Plant Dis. 2009, 93, 852–867. [Google Scholar] [CrossRef] [PubMed] [Green Version]
- Kumari, P.; Singh, R.; Punia, R. Studies on Collection, Isolation, Purification and Maintenance of Culture of Colletotrichum gloeosporioides. Int. J. Agric. Innov. Res. 2017, 6, 351–353. [Google Scholar]
- Riolo, M.; Aloi, F.; Pane, A.; Cara, M.; Cacciola, S.O. Twig and Shoot Dieback of Citrus, a New Disease Caused by Colletotrichum Species. Cells 2021, 10, 449. [Google Scholar] [CrossRef] [PubMed]
- Mammella, M.A.; Martin, F.N.; Cacciola, S.O.; Coffey, M.D.; Faedda, R.; Schena, L. Analyses of the Population Structure in a Global Collection of Phytophthora nicotianae Isolates Inferred from Mitochondrial and Nuclear DNA Sequences. Phytopathology 2013, 103, 610–622. [Google Scholar] [CrossRef] [Green Version]
- Biasi, A.; Martin, F.N.; Cacciola, S.O.; di San Lio, G.M.; Grünwald, N.J.; Schena, L. Genetic Analysis of Phytophthora nicotianae Populations from Different Hosts Using Microsatellite Markers. Phytopathology 2016, 106, 1006–1014. [Google Scholar] [CrossRef] [Green Version]
- Ismail, M.; Zhang, J. Post-Harvest Citrus Diseases and Their Control. Outlook Pest Manag. 2004, 15, 29–35. [Google Scholar] [CrossRef]
- Errampalli, D. Penicillium expansum (Blue Mold). In Postharvest Decay; Elsevier: Amsterdam, The Netherlands, 2014; pp. 189–231. ISBN 978-0-12-411552-1. [Google Scholar]
- Eckert, J.W. The Chemical Control of Postharvest Diseases: Deciduous Fruits, Berries, Vegetables and Root/Tuber Crops. Ann. Rev. Phytopathol. 1988, 26, 433–469. [Google Scholar] [CrossRef]
- Davé, B.; Sales, M.; Walia, M. Resistance of different strains of Penicillium digitatum to imazalil treatment in California citrus packinghouses. Proc. Fla. State Hortic. Soc. 1989, 102, 178–179. [Google Scholar]
- Kanetis, L.; Förster, H.; Adaskaveg, J.E. Comparative Efficacy of the New Postharvest Fungicides Azoxystrobin, Fludioxonil, and Pyrimethanil for Managing Citrus Green Mold. Plant Dis. 2007, 91, 1502–1511. [Google Scholar] [CrossRef] [PubMed] [Green Version]
- Errampalli, D.; Crnko, N. Control of blue mold caused by Penicillium expansum on apples “Empire” with fludioxonil and cyprodinil. Can. J. Plant Pathol. 2004, 26, 70–75. [Google Scholar] [CrossRef]
- Conclusion regarding the peer review of the pesticide risk assessment of the active substance fluoxastrobin. EFSA Sci. Rep. 2007, 102, 1–84. [CrossRef]
- Conclusion regarding the peer review of the pesticide risk assessment of the active substance cyprodinil. EFSA Sci. Rep. 2005, 51, 1–78. [CrossRef]
- Conclusion regarding the peer review of the pesticide risk assessment of the active substance pyrimethanil. EFSA Sci. Rep. 2006, 61, 1–70. [CrossRef] [Green Version]
- Conclusion on the peer review of the pesticide risk assessment of the active substance thiabendazole. EFSA J. 2014, 12, 1–57. [CrossRef] [Green Version]
- Conclusion on the peer review of the pesticide risk Assessment of the active substance azoxystrobin. EFSA J. 2010, 8, 1–110. [CrossRef]
- Conclusion on the peer review of the pesticide risk Assessment of the active substance imazalil. EFSA J. 2010, 8, 1–110. [CrossRef] [Green Version]
- Borrás, A.D.; Aguilar, R.V. Biological control of Penicillium digitatum by Trichoderma viride on postharvest citrus fruits. Int. J. Food Microbiol. 1990, 11, 179–183. [Google Scholar] [CrossRef]
- Del Río, J.A.; Arcas, M.C.; Benavente-García, O.; Ortuño, A. Citrus polymethoxylated flavones can confer resistance against Phytophthora citrophthora, Penicillium digitatum, and Geotrichum species. J. Agric. Food Chem. 1998, 46, 4423–4428. [Google Scholar] [CrossRef]
- Holmes, G.J.; Eckert, J.W. Sensitivity of Penicillium digitatum and P. italicum to Postharvest Citrus Fungicides in California. Phytopathology 1999, 89, 716–721. [Google Scholar] [CrossRef] [Green Version]
- Youssef, K.; Ligorio, A.; Sanzani, S.M.; Nigro, F.; Ippolito, A. Control of storage diseases of citrus by pre- and postharvest application of salts. Postharvest Biol. Technol. 2012, 72, 57–63. [Google Scholar] [CrossRef]
- Youssef, K.; Sanzani, S.M.; Ligorio, A.; Ippolito, A.; Terry, L.A. Sodium carbonate and bicarbonate treatments induce resistance to postharvest green mould on citrus fruit. Postharvest Biol. Technol. 2014, 87, 61–69. [Google Scholar] [CrossRef]
- Abo-Elnaga, H.I.G. Control of green mould of citrus by using Trichoderma harzianum, humic acid or garlic. Arch. Phytopathol. Plant Prot. 2013, 46, 1118–1126. [Google Scholar] [CrossRef]
- Aloui, H.; Licciardello, F.; Khwaldia, K.; Hamdi, M.; Restuccia, C. Physical properties and antifungal activity of bioactive films containing Wickerhamomyces anomalus killer yeast and their application for preservation of oranges and control of postharvest green mold caused by Penicillium digitatum. Int. J. Food Microbiol. 2015, 200, 22–30. [Google Scholar] [CrossRef] [PubMed]
- Fallanaj, F.; Ippolito, A.; Ligorio, A.; Garganese, F.; Zavanella, C.; Sanzani, S.M. Electrolyzed sodium bicarbonate inhibits Penicillium digitatum and induces defence responses against green mould in citrus fruit. Postharvest Biol. Technol. 2016, 115, 18–29. [Google Scholar] [CrossRef]
- Pangallo, S.; Li Destri Nicosia, M.G.; Raphael, G.; Levin, E.; Ballistreri, G.; Cacciola, S.O.; Rapisarda, P.; Droby, S.; Schena, L. Elicitation of resistance responses in grapefruit and lemon fruits treated with a pomegranate peel extract. Plant Pathol. 2017, 66, 633–640. [Google Scholar] [CrossRef]
- Riolo, M.; Aloi, F.; La Spada, F.; Sciandrello, S.; Moricca, S.; Santilli, E.; Pane, A.; Cacciola, S.O. Diversity of Phytophthora Communities across Different Types of Mediterranean Vegetation in a Nature Reserve Area. Forests 2020, 11, 853. [Google Scholar] [CrossRef]
- Aloi, F.; Riolo, M.; Parlascino, R.; Pane, A.; Cacciola, S.O. Bot Gummosis of Lemon (Citrus × Limon) Caused by Neofusicoccum parvum. JoF 2021, 7, 294. [Google Scholar] [CrossRef]
- Wiegand, I.; Hilpert, K.; Hancock, R.E.W. Agar and broth dilution methods to determine the minimal inhibitory concentration (MIC) of antimicrobial substances. Nat. Protoc. 2008, 3, 163–175. [Google Scholar] [CrossRef]

| Phenolic Compounds (mg/kg) | Test Substances | |||
|---|---|---|---|---|
| Water-Extract | EtOAc-Extract | MetOH-Extract | Nitric-Extract | |
| 1-2-Dihydroxybenzene | Nd | 0.48 ± 0.03 | Nd | 0.86 ± 0.02 |
| 3-(4-hydroxy-3-methoxyphenyl) | Nd | Nd | Nd | 0.25 ± 0.03 |
| Benzoic acid | 2.48 ± 0.02 | 3.57 ± 0.04 | 3.08 ± 0.05 | 0.87 ± 0.02 |
| Caffeic acid | 0.16 ± 0.02 | 0.17 ± 0.03 | 0.58 ± 0.01 | 0.16 ± 0.04 |
| Ellagic acid | Nd | Nd | Nd | 0.20 ± 0.01 |
| Gallic acid | Nd | Nd | Nd | Nd |
| Hydroxicinnamic acid | 0.05 ± 0.03 | 0.42 ± 0.01 | 0.27 ± 0.02 | Nd |
| P-Coumaric acid | 0.27 ± 0.02 | 0.34 ± 0.02 | 0.83 ± 0.04 | 0.88 ± 0.01 |
| Sinapic acid | 0.10 ± 0.03 | Nd | Nd | Nd |
| Syringic acid | 0.16 ± 0.02 | Nd | 1.21 ± 0.03 | 0.22 ± 0.01 |
| Vanillic acid | 0.27 ± 0.01 | Nd | Nd | 0.56 ± 0.03 |
| Vanillin | 0.21 ± 0.02 | 0.37 ± 0.03 | 2.04 ± 0.03 | 0.36 ± 0.01 |
| 25% Nitric-Extract (Mean ± SD) | 50% Nitric-Extract (Mean ± SD) | 75% Nitric-Extract (Mean ± SD) | 100% Nitric-Extract (Mean ± SD) | |
|---|---|---|---|---|
| Penicillium digitatum P1PP0 | 14.00 ± 2.65 c 1; (ab) 2 | 20.00 ± 1.00 b; (bc) | 25.00 ± 1.00 a; (bcd) | 26.00 ± 1.00 a; (de) |
| P. commune CECT 20767 | 12.00 ± 1.73 d; (bc) | 23.00 ± 0.00 c; (ab) | 30.00 ± 1.00 b; (bc) | 34.00 ± 1.73 a; (b) |
| P. expansum CECT 2278 | 0.00 ± 0.00 d; (e) | 13.00 ± 1.73 c; (ef) | 22.00 ± 0.00 b; (cdef) | 27.00 ± 1.00 a; (cde) |
| P. italicum CECT 20909 | 0.00 ± 0.00 d; (e) | 12.00 ± 1.73 c; (f) | 20.00 ± 1.73 b; (cdef) | 25.00 ± 0.00 a; (def) |
| Colletotrichum acutatum UW14 | 0.00 ± 0.00 d; (e) | 15.00 ± 1.00 c; (def) | 20.00 ± 0.00 b; (cdef) | 22.00 ± 0.00 a; (efg) |
| C. karsti CAM | 0.00 ± 0.00 c; (e) | 11.00 ± 1.00 b; (f) | 13.00 ± 1.00 b; (f) | 19.00 ± 2.65 a; (gh) |
| C. gloeosporioides C2 | 12.00 ± 1.73 c; (bc) | 15.00 ± 1.00 c; (def) | 23.00 ± 1.73 b; (cdef) | 32.00 ± 3.46 a; (bc) |
| Fusarium proliferatum CBS 145950 | 12.00 ± 1.00 b; (bc) | 13.00 ± 2.65 b; (ef) | 15.00 ± 1.00 ab; (def) | 18.00 ± 1.73 a; (gh) |
| F. sacchari CBS 145949 | 15.00 ± 1.00 c; (ab) | 17.00 ± 1.73 c; (cde) | 21.00 ± 1.73 b; (cdef) | 27.00 ± 0.00 a; (cde) |
| Alternaria arborescens 803 | 0.00 ± 0.00 c; (e) | 12.00 ± 1.73 b; (f) | 18.00 ± 1.73 a; (def) | 20.00 ± 1.73 a; (fgh) |
| A. alternata 646 | 14.00 ± 1.00 c; (ab) | 19.00 ± 1.00 b; (bcd) | 24.00 ± 1.00 a; (bcde) | 25.00 ± 1.73 a; (def) |
| Plenodomus tracheiphilus Pt2 | 10.00 ± 2.00 d; (c) | 15.00 ± 1.73 c; (def) | 34.00 ± 1.00 b; (a) | 43.00 ± 1.00 a; (a) |
| Ph. nicotianae T2.C-M1A | 16.00 ± 1.73 d; (a) | 26.00 ± 1.00 c; (a) | 34.00 ± 0.00 b; (ab) | 30.00 ± 2.65 a; (bcd) |
| Ph. nicotianae T3-B-K1A | 4.00 ± 1.73 d; (d) | 12.00 ± 2.00 c; (f) | 16.00 ± 1.00 b; (def) | 20.00 ± 1.73 a; (fgh) |
| Ph. citrophthora Ax1Ar | 0.00 ± 0.00 c; (e) | 12.00 ± 0.00 b; (f) | 14.00 ± 1.73 ab; (ef) | 16.00 ± 1.00 a; (h) |
| Nitric-Extract (%) | ||
|---|---|---|
| Pathogen (Species, Strains) | MIC | MFC |
| Penicillium digitatum P1PP0 | 3.0 | 3.0 |
| P. commune CECT 20767 | 2.5 | 3.0 |
| P. expansum CECT 2278 | 3.5 | 3.5 |
| P. italicum CECT 20909 | 3.0 | 3.0 |
| Colletotrichum acutatum UW14 | 2.5 | 2.5 |
| C. karsti CAM | 3.0 | 3.0 |
| C. gloeosporioides C2 | 2.0 | 2.0 |
| Fusarium proliferatum CBS 145950 | 3.0 | 3.0 |
| F. sacchari CBS 145949 | 3.5 | 3.5 |
| Alternaria arborescens 803 | 2.5 | 2.5 |
| A. alternata 646 | 2.5 | 3.0 |
| Plenodomus tracheiphilus Pt2 | 2.0 | 2.0 |
| Phytophthora nicotianae T2.C-M1A | 2.5 | 2.5 |
| P. nicotianae T3-B-K1A | 2.0 | 2.5 |
| P. citrophthora Ax1Ar | 2.5 | 3.0 |
| ID of Treatment | Tested Substance |
|---|---|
| ID01 | WATER |
| ID02 | 100% Nitric-extract (NaNO3 0.17 g/mL) |
| ID03 | NaNO3 0.17 g/mL |
| ID04 | 75% Nitric-extract |
| ID05 | NaNO3 0.17 g/mL diluted in sdw at 75% |
| ID06 | 50% Nitric-extract diluted in sdw |
| ID07 | NaNO3 0.17 g/mL diluted in sdw at 50% |
| ID08 | 25% Nitric-extract |
| ID09 | NaNO3 0.17 g/mL diluted in sdw at 25% |
Publisher’s Note: MDPI stays neutral with regard to jurisdictional claims in published maps and institutional affiliations. |
© 2021 by the authors. Licensee MDPI, Basel, Switzerland. This article is an open access article distributed under the terms and conditions of the Creative Commons Attribution (CC BY) license (https://creativecommons.org/licenses/by/4.0/).
Share and Cite
El boumlasy, S.; La Spada, F.; Tuccitto, N.; Marletta, G.; Mínguez, C.L.; Meca, G.; Rovetto, E.I.; Pane, A.; Debdoubi, A.; Cacciola, S.O. Inhibitory Activity of Shrimp Waste Extracts on Fungal and Oomycete Plant Pathogens. Plants 2021, 10, 2452. https://doi.org/10.3390/plants10112452
El boumlasy S, La Spada F, Tuccitto N, Marletta G, Mínguez CL, Meca G, Rovetto EI, Pane A, Debdoubi A, Cacciola SO. Inhibitory Activity of Shrimp Waste Extracts on Fungal and Oomycete Plant Pathogens. Plants. 2021; 10(11):2452. https://doi.org/10.3390/plants10112452
Chicago/Turabian StyleEl boumlasy, Soumia, Federico La Spada, Nunzio Tuccitto, Giovanni Marletta, Carlos Luz Mínguez, Giuseppe Meca, Ermes Ivan Rovetto, Antonella Pane, Abderrahmane Debdoubi, and Santa Olga Cacciola. 2021. "Inhibitory Activity of Shrimp Waste Extracts on Fungal and Oomycete Plant Pathogens" Plants 10, no. 11: 2452. https://doi.org/10.3390/plants10112452
APA StyleEl boumlasy, S., La Spada, F., Tuccitto, N., Marletta, G., Mínguez, C. L., Meca, G., Rovetto, E. I., Pane, A., Debdoubi, A., & Cacciola, S. O. (2021). Inhibitory Activity of Shrimp Waste Extracts on Fungal and Oomycete Plant Pathogens. Plants, 10(11), 2452. https://doi.org/10.3390/plants10112452

